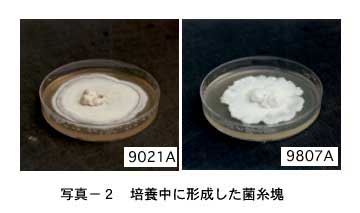
キノコ菌糸100%のレザー質感新素材シートキノコの皮KINOLISENSE-Laboratory

きのこ 菌糸とは (360 無料画像)
菌糸から育てた天然素材MYCL — MYCL Japan。
菌糸 キンシ とは? 意味や使い方 - コトバンク。
キノコ菌糸100%のレザー質感新素材シートキノコの皮KINOLISENSE-Laboratory。
雨後のキノコの電気的な会話を測定-菌糸のネットワークによるシグナル伝達の可能性を野外で初確認-京都大学。
Amazon月夜野きのこ園 菌糸ビン E-1400クワガタ幼虫用月夜野きのこ園餌 通販。
暮らしの科学 第41回 カビやヒトとも近い? キノコの不思議。
森の達人に学ぼうHondaWoods 元気な森を次世代のために、地域のために。
13,500点を超える菌糸のストックフォト、写真、そしてロイヤリティフリーの画像 - iStock細胞, ミズナラ, 火星。
キノコは「菌糸ネットワークを流れる電気信号」で会話をしている - ナゾロジ。
オオクワガタの幼虫飼育でオオヒラタケ菌糸ビンにキノコが生えてきた旅館番頭の佐渡観光情報ブログ。
菌糸から育てた天然素材MYCL — MYCL Japan。
キノコの分子育種・成長因子の解析、子実体誘導機構の解明。
土屋鞄 国内初、キノコの菌糸体由来の素材「Mylo™️」を採用した新製品を発売株式会社土屋鞄製造所のプレスリリース。
自然と未来をつなぐ「菌糸でつくるマテリアル作りワークショップ」 - FabCafe Global。
トップ>キッズトップ>生活>キノコ>菌 きん 類のなかま。
きのこの胞子・菌糸のはなしおいしいきのこ 魚沼きのこ。
寒さ好きの菌類たちは、いかに雪腐病菌になったか 後編菌は語る――ミクロの開拓者たちの生きざまと知性 星野保web春秋 はるとあき。
森林研究所たより きのこの交配の話 林業にいがた2019年08月号記事- 新潟県ホームページ。
Growing Enoki mycelium 🍄🟫 , 市販えのきからえのきの菌糸を培養する様子。, まずはきのこ菌糸体を育てる。,きのこが分解して餌にするのは糖分や食物繊維。, 通常えのきやエリンギなどの腐生菌類のきのこは倒木や枯葉などを分解するが,人間界ではゴミとなる新聞紙やダンボール、トイレットペーパー、コーヒーや茶殻などの植物繊維を使うことができる。,。
きのこの結婚きのこ百科 一般財団法人日本きのこセンター。
キノコ菌糸100%のレザー質感新素材シートキノコの皮KINOLISENSE-Laboratory。
キノコも焦らされると決断を急ぐ!? 〜菌類の認知行プレスリリース・研究成果東北大学 -TOHOKU UNIVERSITY。
きのこ豆知識 分類から見る「菌類」という生きものきのこびと。
真菌類 キノコ・カビ・酵母– 北海道大学 理学部 生物科学科 生物学。
土屋鞄 国内初、キノコの菌糸体由来の素材「Mylo™️」を採用した新製品を発売株式会社土屋鞄製造所のプレスリリース。
13,500点を超える菌糸のストックフォト、写真、そしてロイヤリティフリーの画像 - iStock細胞, ミズナラ, 火星。
宮西ナオ子のがんに挑むサプリメント 徹底リサーチ 第2回 シイタケ菌糸体がんの先進医療蕗書房。
Growing Enoki mycelium 🍄🟫 市販えのきからえのきの菌糸を培養する様子。 まずはきのこ菌糸体を育てる。 きのこ が分解して餌にするのは糖分や食物繊維。 通常えのきやエリンギなどの腐生菌類のきのこは倒木や枯葉などを分解するが 人間界ではゴミとなる新聞紙や。
キノコの菌糸体から人工レザーを作るアメリカの企業「Bolt Threads」 – J-WAVE 81.3 FM JK RADIO TOKYOUNITED。
菌床きのこ栽培における害菌と対策」1.害菌の種類と特徴 - YouTube。
業界初 キノコ菌糸100%素材「KINOLI®」×人気VTuber「奇ノ駒たんご」MYCL Japan株式会社のプレスリリース。
きのこのからだきのこ百科 一般財団法人日本きのこセンター。
森の達人に学ぼうHondaWoods 元気な森を次世代のために、地域のために。
中国キノコ菌糸体プラグスポーン椎茸プラグのメーカーとサプライヤー 中国七河。
きのこ習慣自家製ヨーグルトの手作り用「種菌」 - 株式会社ケフラン 日本ケフィア直営 公式 オンラインショップ。
きのこのからだきのこ百科 一般財団法人日本きのこセンター。
ハタケシメジにカビが生えている野菜商品Q&Aコープこうべ 商品検査センタ。